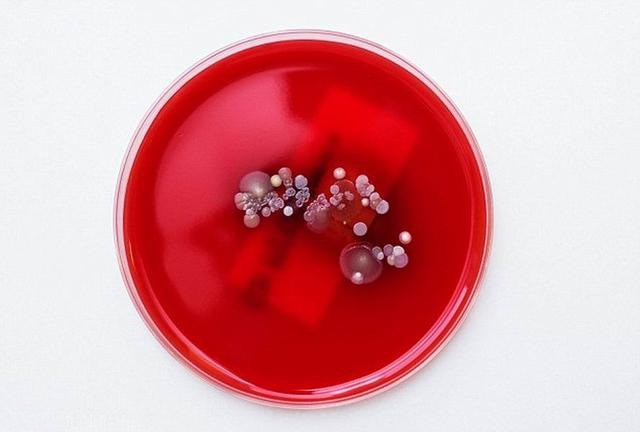

53、美國泰雷茲THALES:主要產(chǎn)品有全球衛(wèi)星定位儀、GPS導(dǎo)航儀、GPS接收機(jī)、GIS數(shù)據(jù)采集器。54、美國愛思進(jìn)AXYGEN:美國Axygen公司是一家位于硅谷地區(qū)的高科技企業(yè),主要產(chǎn)品為實(shí)驗(yàn)室耗材,包括:吸頭、PCR薄壁管、PCR板、PCR封口膜、離心管、離心管架和分離柱。Axygen公司的產(chǎn)品具有多項(xiàng)目專利和領(lǐng)先技術(shù),如:模具金剛石拋光技術(shù);MAX…
時(shí)間:
2016-07-20 14:09:49
查看詳情+